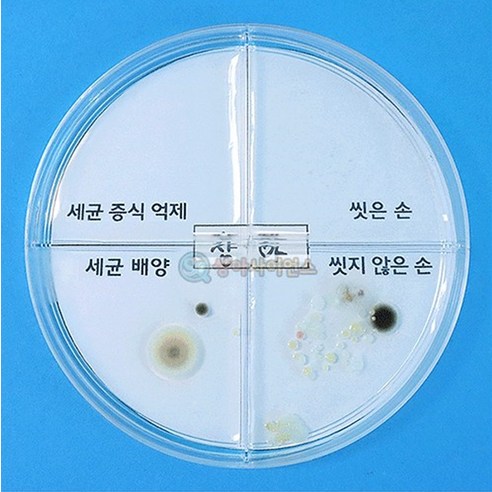
Product image

최근본상품
(SA) 세균 배양과 증식 억제 실험하기(4인)
11,590원
배송비
4,400원
목요일 3/5 도착 예정
판매자:아아몰9호점
판매자 평가 -- %(14건 이하의 평가)
-- %(14건 이하의 평가)
 -- %(14건 이하의 평가)
-- %(14건 이하의 평가)배송사: 업체직송
적립
최대 580원· 쿠페이 머니 결제시
혜택보기
PC에서도 간편한 결제 쿠페이머니
쿠페이머니 카드
카드 계좌이체
계좌이체
 쿠페이머니
쿠페이머니 카드
카드 계좌이체
계좌이체- 학습과목: 과학영역
- 쿠팡상품번호: 9152991447 - 26953733878
필수 표기 정보
필수 표기 정보 더보기더보기
판매자가 현금거래를 요구하면 거부하시고 즉시 사기 거래 신고센터 (1670-9832)에 신고하시기 바랍니다.
상품 리뷰
동일한 상품에 대해 작성된 상품 리뷰로, 판매자는 다를 수 있습니다.
동일한 상품에 대해 작성된 상품 리뷰로, 판매자는 다를 수 있습니다.
등록된 상품평이 없습니다.
상품문의
- 구매한 상품의 취소/반품은 마이쿠팡 구매내역에서 신청 가능합니다.
- 상품문의 및 후기게시판을 통해 취소나 환불, 반품 등은 처리되지 않습니다.
- 가격, 판매자, 교환/환불 및 배송 등 해당 상품 자체와 관련 없는 문의는 고객센터 내 1:1 문의하기를 이용해주세요.
- "해당 상품 자체"와 관계없는 글, 양도, 광고성, 욕설, 비방, 도배 등의 글은 예고 없이 이동, 노출제한, 삭제 등의 조치가 취해질 수 있습니다.
- 공개 게시판이므로 전화번호, 메일 주소 등 고객님의 소중한 개인정보는 절대 남기지 말아주세요.
아직 문의가 없습니다.
판매 부적격 상품 또는 허위과장광고 및 지식재산권을 침해하는 상품의 경우 신고하여 주시기 바랍니다.







